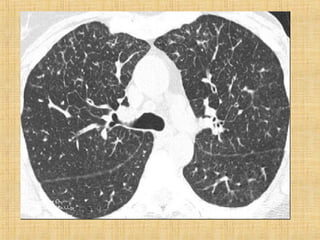

Incorporar apresentação
Baixar para ler offline



































As principais informações do documento são: 1. Discute os padrões de doença pulmonar causados por metástases, incluindo nódulos, espessamento intersticial e obstrução das vias aéreas. 2. A prevalência de metástases pulmonares varia de 30-55% dependendo do tumor primário, e são mais comuns em pacientes acima de 50 anos. 3. Os achados clínicos mais comuns são dispneia, hemoptise e febre, enquanto exames de escarro ou lavado brô